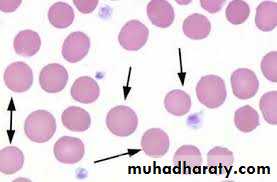

Hemolytic anaemia
عنوان فرعيIt is defined as anemia due to shortened RBCs life span .
Evidence of hemolysis :1- Increased RBCs breakdown .
A- Anemia .
B- Increased indirect hyperbilirubinemia .
C- Increased fecal and urine urobilinogen .
D- Decreased serum haptogobin .
E- Increased serum LDH .
F- Shortened RBCs life span by radiolabelled studies .
G- Hemoglobinuria .
2- Increased bone marrow activity :
A- Increased reticulocyte count ( Polychromasia )B- Erythroid hyperplasia on bone marrow study .
Types of hemolysis :
1- Extra – vascular hemolysis : in RES in Spleen , liver , BM .
2- Intra – vascular hemolysis : associated with hemoglobinuria ,
hemoglobinaemia and usually seen in paroxysmal nocturnal
hemoglobinuria , incompatible blood transfusion .
Classification :
A- Intrinsic defect1- Membrane defect : ex : hereditary spherocytosis .
2- Hemoglobinopathies : Thalassemia and sickle cell anemia .
3- Enzymatic defect : G6PDD
4- PNH : acquired .
B- Extrinsic defect
1- Immune : Warm and cold autoimmune hemolytic anemia .2- Non – immune : infection , burn , snake bite
Hereditary spherocytosis
It is an autosomal dominant condition ; yet 30% of patients have no family history of the disease .It occurs due to deficiency of spectrin in the RBCs membrane leading to damage in RES because the cells cannot pass the capillaries and venous sinusdoids of the spleen .
Clinical features :
1- Long standing anemia .
2- jaundice .
3- Splenomegaly .
4- Pigmented gallstones .
5- Leg ulcers .
6- Sudden reduction in the Hb due to parvovirus infection .
Investigation :
1- anemia .2- Reticulocytosis .
3- Increased indirect hyperbilirubinemia .
4- Spherocytes ( RBCs ) in blood film .
5- Positive osmotic fragility test .
6- negative coomb’s test .
Spherocytosis my be seen in :
1- Hereditory spherocytosis .2- autoimmune hemolytic anemia .
To differentiate between them we do coomb’s test
if +ve……………….. AIHA
if –ve ……………….. Hereditory spherocytosis .
Treatment :
1- Splenectomy ( the best treatment )
The idea is to remove the site of hemolysis .
It is indicated in :
A- Severe cases .
B- Any death in the family due to the same disease .
C- Frequent transfusion .
2- Folic acid .
3- Blood transfusion ( packed RBCs ) in symptomatic anemia .